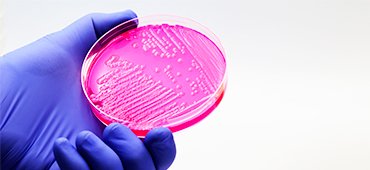
The role of the microbiome in dermatological conditions

SkinAlliance is a medical education program whose mission is to raise awareness on scientific territories related to skin and hair care. In the frame of this, we believe accredited courses are the best way for healthcare professional to build their knowledge.
See below our SkinAlliance accredited courses by XPEER in both dermatology and dermocosmetics.

Learning objective: Understand the role of dermocosmetics in various skin conditions: atopic dermatitis, acne, skin cancer... Include recent guidelines. An overview course to start on the topic.
Recommended audience: General practitioners, Pharmacists, Nurses
Course in English, Italian, German
Learning objective: Understand the important role of the skin microbiome in diseases like acne, cancer, atopic dermatitis and solution to improve your microbiome
Recommended audience: Dermatologists, General practitioners, Pharmacists
Course in English, Chinese

Learning objective: Understand the skin's susceptibility to different factors
Recommended audience: Dermatologists, General practitioners, Pharmacists, Gynecologists
Course in English

Understand the impact of the COVID-19 pandemic on dermatology practice and the emergence of skin conditions
Recommended audience: Dermatologists, Aesthetics Doctors
Course in English
Information about CME accreditation
Completion of the course will allow you to gain European credits from the European Accreditation Council for CME (EACCME). EACME are recognized in the following countries: Armenia, Austria, Belgium, Bulgaria, Croatia, Cyprus, Finland, Georgia, Greece, Hungary, Ireland, Italy, Luxembourg, Malta, Norway, Poland, Portugal, Romania, Slovakia, Slovenia, Spain, Sweden, Tunisia, Turkey, United Kingdom, USA.
EACME credits can be converted in American Medical Association credits (AMA). They are also recognized outside Europe on a voluntary basis. Please liaise with your local accreditation entity for information and conversion.